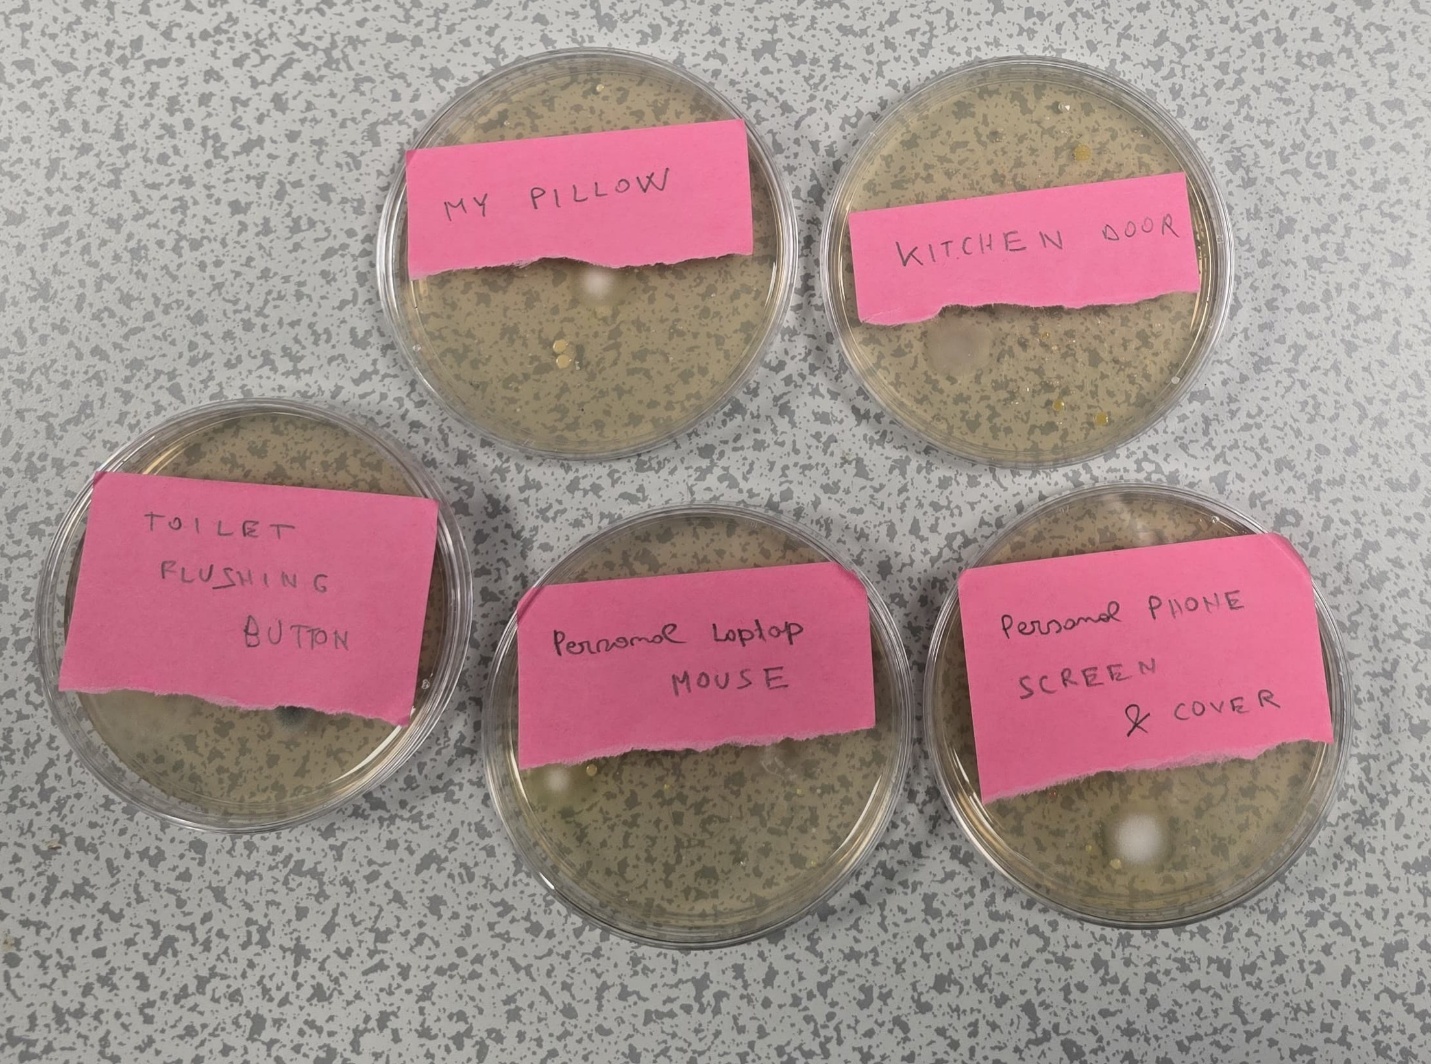
Environmental service

Environment

Scroll to see all photos →
- Preparation of Environmental Impact Assessment (EIA) reports in compliance with Albanian legislation
- Preparation of Environmental and Social Impact Assessments (ESIA) in line with international standards (IFC, EBRD)
- Organization and coordination of public hearings and stakeholder consultation processes
- Public presentation and communication of project information to local communities
- Development of Environmental and Social Management Plans (ESMPs) for construction and industrial projects (noise, dust, traffic, etc.)
- Design, implementation and monitoring of Construction Environmental and Social Management Systems (CESMS)
- Environmental accident assessment and preparation of environmental and legal expert reports
- Provision of environmental due diligence services for infrastructure projects
- Preparation of environmental risk assessment reports for companies
- Advisory services on decarbonization and greenhouse gas reduction strategies
- Development of carbon accounting tools and calculation methodologies tailored to company activities
- Maintenance and improvement of greenhouse gas reporting systems
- Environmental audits in accordance with Albanian legislation
- Environmental audits based on ISO 14001 standards
- Establishment, maintenance and internal auditing of Environmental Management Systems (ISO 14001)
- Technical assistance for environmental permits (Type A and B)
- Technical support for obtaining License III.2.B
- Technical assistance for water abstraction permits (groundwater wells)
- Preparation of environmental self-monitoring reports in compliance with permit requirements
- Assistance with periodic waste reporting for companies with Unique Codes
- Support in preparing tender documentation for municipal waste management services
- Preparation of Pollutant Release and Transfer Registers (PRTR)
- Technical and legal support during environmental inspections
- Consultancy on waste management practices (reduction, reuse, recycling, incineration, landfill)
- Ambient air quality monitoring (gases, dust, noise)
- Indoor air quality monitoring (dust, noise, gases, lighting)
- Sampling and physico-chemical and bacteriological analysis of water and liquids
- Soil sampling and analysis
- Interpretation and reporting of laboratory and monitoring data
- Development of action plans to improve air, water and soil quality
- Studies and remediation planning for contaminated land in industrial areas
- Design and installation of environmental awareness signage
- Creation and optional printing of awareness materials (leaflets, banners, posters)
- Consultancy for environmental communication and social media management
- Analysis and approximation of environmental legislation with EU acquis
- Technical advisory in drafting environmental strategies, plans and secondary legislation
- Support in policy development and institutional coordination aligned with EU and donor requirements





















